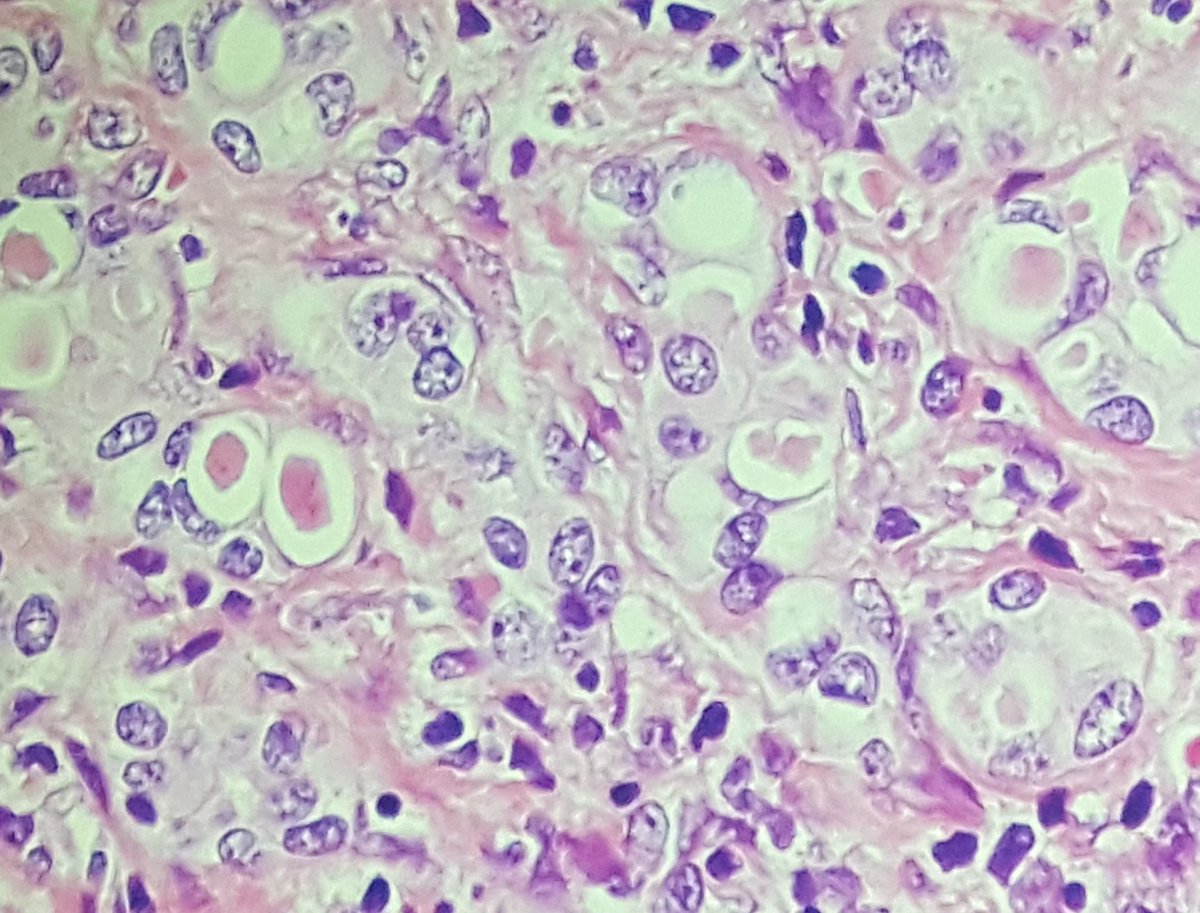
Sanjay Kakar tweet media

Check out this textbook at the Elsevier booth at USCAP. @Elsevier @USGIPS @LiverPath_HPHS @TheUSCAP @AIPNAPathology

English
Sanjay Kakar
37 posts















Come join us at the #USCAP2020 annual meeting in Los Angeles! bit.ly/2SmeyMK Sat Feb 29 (6-8PM) HPHS Reception & Sun March 1 (8:30-noon) Companion Meeting! Plan to come early as it was a packed house and much fun last year! Pictures of our reception from #USCAP2019